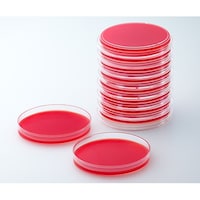
���{�x�N�g���E�f�B�b�L���\���@�a�c�@�a�a�k�i�s�l�j�@�s�r�`�h�h�T���q�c�W���t���V�|�n�@�Q�O��

Merck 粉末培地 (緩衝ペプトン水) 500g 1.07228.0500 培地 培地(食品検査用) 1個
Merckの「粉末培地 (緩衝ペプトン水) 500g」は、品質と信頼性に優れた人気商品です。
Merckの「粉末培地 (緩衝ペプトン水) 500g」は、品質と信頼性に優れた人気商品です。+もっと見る
Merck 培地添加剤(テルル酸卵黄エマルジョン) 1.03785.0050 培地 培地(食品検査用) 1個
Merckの「培地添加剤(テルル酸卵黄エマルジョン)」は、品質と信頼性に優れた人気商品です。
Merckの「培地添加剤(テルル酸卵黄エマルジョン)」は、品質と信頼性に優れた人気商品です。+もっと見る
日本ベクトン・ディッキンソン BD BBL(TM) トリプチケース(TM) ソイ寒天培地 20枚 251185 培地 簡易培地 1個(20枚)
トリプチケースソイ寒天培地は空中落下細菌試験、各種無菌試験用に使用されます
トリプチケースソイ寒天培地は空中落下細菌試験、各種無菌試験用に使用されます+もっと見る
日本ベクトン・ディッキンソン BD Difco(TM) トリプティックソイ血液寒天基礎培地 No.2 227300 培地 その他 1個
溶血性反応が重要な場合、血液を添加して、培養条件の難しい微生物の分離に使用します。
溶血性反応が重要な場合、血液を添加して、培養条件の難しい微生物の分離に使用します。+もっと見る
日本ベクトン・ディッキンソン BD Difco(TM) MUG添加バイオレットレッド胆汁寒天培地 229100 分析・検査 培地 1個
乳製品および食物からの腸内細菌の選択分離並びに大腸菌を発光酵素基質法で検出します。
乳製品および食物からの腸内細菌の選択分離並びに大腸菌を発光酵素基質法で検出します。+もっと見る
アズワン サニスペック粉末培地
+もっと見る
日本ベクトン・ディッキンソン BD BBL(TM) サブローデキストロース寒天培地 20枚 251180
サブローデキストロース寒天培地は、さまざまな検査材料から病原性あるいは、非病原性の真菌を分離・培養するのに適しています
サブローデキストロース寒天培地は、さまざまな検査材料から病原性あるいは、非病原性の真菌を分離・培養するのに適しています+もっと見る
日本ベクトン・ディッキンソン BD BBL(TM) ミューラーヒントンII寒天培地 100枚
ミューラーヒントンII 寒天培地は、KirbyBauer 法に基く薬剤感受性テスト用培地で、CLSI M2A9 により推奨されています
ミューラーヒントンII 寒天培地は、KirbyBauer 法に基く薬剤感受性テスト用培地で、CLSI M2A9 により推奨されています+もっと見る
日本ベクトン・ディッキンソン BD BBL(TM) ブレインハートインフュージョン寒天培地 20枚
ブレインハートインフュージョン(BHI)寒天培地は臨床、非臨床の各種検体から好気性、嫌気性を問わず多種類の微生物を培養できる培地です
ブレインハートインフュージョン(BHI)寒天培地は臨床、非臨床の各種検体から好気性、嫌気性を問わず多種類の微生物を培養できる培地です+もっと見る
日本ベクトン・ディッキンソン BD BBL(TM) ミューラーヒントンII寒天培地 20枚
ミューラーヒントンII 寒天培地は、KirbyBauer 法に基く薬剤感受性テスト用培地で、CLSI M2A9 により推奨されています
ミューラーヒントンII 寒天培地は、KirbyBauer 法に基く薬剤感受性テスト用培地で、CLSI M2A9 により推奨されています+もっと見る
日本ベクトン・ディッキンソン BD BBL(TM)ポテトデキストロースCP 寒天培地 1個(1本×20枚入)
食品検査に用いらるクロラムフェニコール入りの酵母及びカビ用です。常温保存で6か月の有効期限です。
食品検査に用いらるクロラムフェニコール入りの酵母及びカビ用です。常温保存で6か月の有効期限です。+もっと見る
極東製薬工業 生培地(バイタルメディア) DHL寒天培地 サルモネラシゲラの選択分離培養 20枚入 05441
高品質の生培地です。培地調製の手間が省け、ムダがありません。
高品質の生培地です。培地調製の手間が省け、ムダがありません。+もっと見る
Merck 粉末培地 (チオグリコレイトブイヨン(チオグリコール酸培地2)) 500g 1.08190.0500 培地 培地(食品検査用) 1個
Merckの「粉末培地 (チオグリコレイトブイヨン(チオグリコール酸培地2)) 500g」は、品質と信頼性に優れた人気商品です。
Merckの「粉末培地 (チオグリコレイトブイヨン(チオグリコール酸培地2)) 500g」は、品質と信頼性に優れた人気商品です。+もっと見る
Merck 粉末培地 (ペプトン加生理食塩水) 500g 1.12535.0500 培地 培地(食品検査用) 1個
Merckの「粉末培地 (ペプトン加生理食塩水) 500g」は、品質と信頼性に優れた人気商品です。
Merckの「粉末培地 (ペプトン加生理食塩水) 500g」は、品質と信頼性に優れた人気商品です。+もっと見る
日本ベクトン・ディッキンソン フェニルエチルアルコール 5%羊血液寒培地 20枚 212086 培地 その他 1個(20枚)
フェニルエチルアルコール5%ヒツジ血液寒天培地は、StreptococcusやStaphylococcusなどのグラム陽性球菌の選択的分離に用いられます
フェニルエチルアルコール5%ヒツジ血液寒天培地は、StreptococcusやStaphylococcusなどのグラム陽性球菌の選択的分離に用いられます+もっと見る
日本ベクトン・ディッキンソン BD BBL(TM) キャンピロバクター 10%ヒツジ血液寒天培地 20枚 251727 培地 その他 1個(20枚)
本培地は、Campylobacter特にC.jejuniを糞便検体から選択分離するのに適した培地です
本培地は、Campylobacter特にC.jejuniを糞便検体から選択分離するのに適した培地です+もっと見る
日本ベクトン・ディッキンソン BD BBL(TM) スキロー培地 20枚 252111 培地 簡易培地 1個(20枚)
スキロー培地は、Campylobacter特にC.jejiuniを糞便検体から選択分離するのに適した培地です
スキロー培地は、Campylobacter特にC.jejiuniを糞便検体から選択分離するのに適した培地です+もっと見る
Merck コンタクトスライド ローズベンガル寒天培地 未滅菌 1箱(20枚入) YM
アイソレーターやクリーンルームで表面付着菌を測定できます。2重個別包装でコンタミネーションを防ぎます。室温で長期保存が可能です。
アイソレーターやクリーンルームで表面付着菌を測定できます。2重個別包装でコンタミネーションを防ぎます。室温で長期保存が可能です。+もっと見る
Merck アンプル培地 (大腸菌群用)1箱(50枚入) MHA000P2E
2mLプラスチックアンプルに密封充填された液体培地ですので、ガラスアンプルのようなカッティング操作はありません。
2mLプラスチックアンプルに密封充填された液体培地ですので、ガラスアンプルのようなカッティング操作はありません。+もっと見る
Merck アンプル培地 (カビ・酵母用)1箱(50枚入) MHA000P2N
2mLプラスチックアンプルに密封充填された液体培地ですので、ガラスアンプルの様なカッティング操作が不要です。
2mLプラスチックアンプルに密封充填された液体培地ですので、ガラスアンプルの様なカッティング操作が不要です。+もっと見る
Merck リステリア測定用培地 クロモカルトリステリア選択剤 リステリアの選択培地用添加剤 1箱(10本入) 1.00432.0010
Readybag(R)で一次増菌を行った後、選択増菌及び選択分離を行います。
Readybag(R)で一次増菌を行った後、選択増菌及び選択分離を行います。+もっと見る
Merck Readybag(R)顆粒培地 緩衝ペプトン水 1箱(60包入) 1.00901.0001
秤量済で、滅菌済精製水を加えるだけで調製ができます。1次増菌を行ったのち、選択増菌及び選択分離を行います。
秤量済で、滅菌済精製水を加えるだけで調製ができます。1次増菌を行ったのち、選択増菌及び選択分離を行います。+もっと見る
日本ベクトン・ディッキンソン BD BBL(TM) トリプチケース(TM) ソイブロス 500g 211768 1個
BD BBL(TM) トリプチケース(TM)ソイ寒天培地の寒天を抜いた製品で、製造ライン洗浄や増菌、菌液調整等の幅広い検査に使用します。
BD BBL(TM) トリプチケース(TM)ソイ寒天培地の寒天を抜いた製品で、製造ライン洗浄や増菌、菌液調整等の幅広い検査に使用します。+もっと見る
日本ベクトン・ディッキンソン BD BBL(TM) 卵黄加マンニット食塩寒天培地 20枚
卵黄加マンニット食塩寒天培地は臨床材料、食品等から黄色ブドウ球菌の選択分離および生菌数の検査に用いられます
卵黄加マンニット食塩寒天培地は臨床材料、食品等から黄色ブドウ球菌の選択分離および生菌数の検査に用いられます+もっと見る
日本ベクトン・ディッキンソン BD BBL(TM) XLD寒天培地 20枚
XLD寒天培地は、グラム陰性桿菌、特にShigellaの分離に適した選択培地です。選択剤のデスオキシコール酸ナトリウムは、グラム陽性菌の発育を抑制します
XLD寒天培地は、グラム陰性桿菌、特にShigellaの分離に適した選択培地です。選択剤のデスオキシコール酸ナトリウムは、グラム陽性菌の発育を抑制します+もっと見る
極東製薬工業 生培地(バイタルメディア) CTSMAC寒天培地 腸管出血性大腸菌O157分離用 20枚入 05431
高品質の生培地です。培地調製の手間が省け、ムダがありません。
高品質の生培地です。培地調製の手間が省け、ムダがありません。+もっと見る
サン化学 サンコリ簡易菌検出紙 (大腸菌群用)1箱(100枚入) 00001 培地 簡易培地 1箱(100枚)
検出紙に検液を浸し、35から37℃で24時間培養するだけの簡易型菌検出紙です。
検出紙に検液を浸し、35から37℃で24時間培養するだけの簡易型菌検出紙です。+もっと見る
サン化学 サンコリ簡易菌検出紙 (ブドウ球菌用)1箱(100枚入) 00002 培地 簡易培地 1箱(100枚)
検出紙に検液を浸し、35から37℃で24時間培養するだけの簡易型菌検出紙です。
検出紙に検液を浸し、35から37℃で24時間培養するだけの簡易型菌検出紙です。+もっと見る
サン化学 サンコリ簡易菌検出紙 (一般細菌用)1箱(100枚入) 00003 培地 簡易培地 1箱(100枚)
検出紙に検液を浸し、35から37℃で24時間培養するだけの簡易型菌検出紙です。
検出紙に検液を浸し、35から37℃で24時間培養するだけの簡易型菌検出紙です。+もっと見る
サン化学 簡易菌検出紙 (大腸菌群XTYPE)1箱(100枚入) 00006 培地 簡易培地 1箱(100枚)
検出紙に検液を浸し、35から37℃で24時間培養するだけの簡易型菌検出紙です。
検出紙に検液を浸し、35から37℃で24時間培養するだけの簡易型菌検出紙です。+もっと見る
日本ベクトン・ディッキンソン BD BBL(TM) CA添加5%ヒツジ血液寒天培地(M) 20枚 252355 培地 その他 1個(20枚)
ヒツジ血液寒天培地(M)にコリスチンとアズトレオナムを添加しているため、グラム陽性菌の選択に適した培地です
ヒツジ血液寒天培地(M)にコリスチンとアズトレオナムを添加しているため、グラム陽性菌の選択に適した培地です+もっと見る
日本ベクトン・ディッキンソン BD Difco(TM) デュボスアルブミン培地(20mL)1個(10本入) 215334 培地 その他 1個(10本)
ベクトン・ディッキンソンの「BD Difco(TM) デュボスアルブミン培地(20mL)1個(10本入)」は、品質と信頼性に優れた人気商品です。
ベクトン・ディッキンソンの「BD Difco(TM) デュボスアルブミン培地(20mL)1個(10本入)」は、品質と信頼性に優れた人気商品です。+もっと見る
Merck アンプル培地 (一般生菌用/TCC添加)1箱(50枚入) MHA00P2TT
2mLプラスチックアンプルに密封充填された液体培地ですので、ガラスアンプルのようなカッティング操作はありません。
2mLプラスチックアンプルに密封充填された液体培地ですので、ガラスアンプルのようなカッティング操作はありません。+もっと見る
日本ベクトン・ディッキンソン BD BBL(TM) ヒツジ血液寒天培地(Z) 100枚
ヒツジ血液寒天培地Zは、TSAII5%ヒツジ血液寒天培地をベースに、栄養要求の厳しい肺炎球菌の発育支持力を改良した培地です。
ヒツジ血液寒天培地Zは、TSAII5%ヒツジ血液寒天培地をベースに、栄養要求の厳しい肺炎球菌の発育支持力を改良した培地です。+もっと見る
ADVANTEC 培地SKM1020
+もっと見る
PALL Broth
+もっと見る
日本ベクトン・ディッキンソン BD ロダック(TM) プレート SCDLP寒天培地 1個(1本×30枚入)
日本薬局方の環境試験用スタンプ式の培地ですが、非無菌エリア用となります。中和剤としてレシチン、ポリソルベートが含有されてます。
日本薬局方の環境試験用スタンプ式の培地ですが、非無菌エリア用となります。中和剤としてレシチン、ポリソルベートが含有されてます。+もっと見る
日本ベクトン・ディッキンソン BD BBL(TM) ヒツジ血液寒天培地(T) 20枚
ヒツジ血液寒天培地(T) は臨床材料からの溶血レンサ球菌の分離・溶血反応の鑑別、栄養要求の厳しい細菌の分離培養のために使用されます
ヒツジ血液寒天培地(T) は臨床材料からの溶血レンサ球菌の分離・溶血反応の鑑別、栄養要求の厳しい細菌の分離培養のために使用されます+もっと見る
日本ベクトン・ディッキンソン BD BBL(TM) ヒツジ血液寒天培地(Z) 20枚
ヒツジ血液寒天培地Zは、TSAII5%ヒツジ血液寒天培地をベースに、栄養要求の厳しい肺炎球菌の発育支持力を改良した培地です。
ヒツジ血液寒天培地Zは、TSAII5%ヒツジ血液寒天培地をベースに、栄養要求の厳しい肺炎球菌の発育支持力を改良した培地です。+もっと見る
日本ベクトン・ディッキンソン BD BBL(TM) コロンビア5%ヒツジ血液寒天培地 20枚
コロンビア5%ヒツジ血液寒天培地はコロンビア寒天培地を基礎培地に5%ヒツジ脱線維血液を加え、発育性にすぐれた一般細菌分離用培地です
コロンビア5%ヒツジ血液寒天培地はコロンビア寒天培地を基礎培地に5%ヒツジ脱線維血液を加え、発育性にすぐれた一般細菌分離用培地です+もっと見る
日本ベクトン・ディッキンソン BD BBL(TM) TSAII5%ヒツジ血液寒天培地 20枚
TSAII 5%ヒツジ血液寒天培地は臨床材料からの溶血レンサ球菌の分離・溶血反応の鑑別、栄養要求の厳しい細菌の分離培養のために使用されます
TSAII 5%ヒツジ血液寒天培地は臨床材料からの溶血レンサ球菌の分離・溶血反応の鑑別、栄養要求の厳しい細菌の分離培養のために使用されます+もっと見る
日本ベクトン・ディッキンソン BD BBL(TM) TSAII5%ヒツジ血液寒天培地 100枚
TSAII 5%ヒツジ血液寒天培地は臨床材料からの溶血レンサ球菌の分離・溶血反応の鑑別、栄養要求の厳しい細菌の分離培養のために使用されます
TSAII 5%ヒツジ血液寒天培地は臨床材料からの溶血レンサ球菌の分離・溶血反応の鑑別、栄養要求の厳しい細菌の分離培養のために使用されます+もっと見る
日本ベクトン・ディッキンソン BD BBL(TM) コロンビアCNA5%ヒツジ血液寒天培地 20枚 251352 培地 その他 1個(20枚)
コロンビアCNA5%ヒツジ血液寒天培地は、様々な菌が混在する検査材料から、グラム陽性球菌の選択的分離に用いるのにおすすめ
コロンビアCNA5%ヒツジ血液寒天培地は、様々な菌が混在する検査材料から、グラム陽性球菌の選択的分離に用いるのにおすすめ+もっと見る
日本ベクトン・ディッキンソン BD Difco(TM) ロゾリック酸 1個(6包入) 232281 培地 その他 1個(6包)
MFCブロス基礎培地(No.288320)およびMFC寒天培地(No.267710)に添加して、腸内細菌の検出および菌数測定に使用します。
MFCブロス基礎培地(No.288320)およびMFC寒天培地(No.267710)に添加して、腸内細菌の検出および菌数測定に使用します。+もっと見る
Merck クリーンルーム用環境測定培地 1ケース(20枚入) SCD LT ICR90
耐乾燥性に優れ、培地表面がひび割れにくいです。アイソレーター及びクリーンルーム対応です。3重包装で、内袋にはガス滅菌用の吊り穴が付いています。
耐乾燥性に優れ、培地表面がひび割れにくいです。アイソレーター及びクリーンルーム対応です。3重包装で、内袋にはガス滅菌用の吊り穴が付いています。+もっと見る
Merck クリーンルーム用環境測定培地SCD LTHThICR90 1ケース(20枚入) SCD LTHTh ICR90
耐乾燥性に優れ、培地表面がひび割れにくいです。アイソレーター及びクリーンルーム対応です。3重包装で、内袋にはガス滅菌用の吊り穴が付いています。
耐乾燥性に優れ、培地表面がひび割れにくいです。アイソレーター及びクリーンルーム対応です。3重包装で、内袋にはガス滅菌用の吊り穴が付いています。+もっと見る
Merck クリーンルーム用環境測定培地 1ケース(20枚入) サブローLTHTh
耐乾燥性に優れ、培地表面がひび割れにくいです。アイソレーター及びクリーンルーム対応です。3重包装で、内袋にはガス滅菌用の吊り穴が付いています。
耐乾燥性に優れ、培地表面がひび割れにくいです。アイソレーター及びクリーンルーム対応です。3重包装で、内袋にはガス滅菌用の吊り穴が付いています。+もっと見る
Merck リステリア測定用培地 クロモカルトリステリア選択剤 リステリア増菌剤 1箱(10本入) 1.00439.0010
Readybag(R)で一次増菌を行った後、選択増菌及び選択分離を行います。クロモカルトリステリア(ALOA寒天培地3360503)に添加して使用します。
Readybag(R)で一次増菌を行った後、選択増菌及び選択分離を行います。クロモカルトリステリア(ALOA寒天培地3360503)に添加して使用します。+もっと見る
日本ベクトン・ディッキンソン BD BBL(TM) CIN寒天培地 20枚
CIN 寒天培地は、検査材料からのYersinia の選択分離培地です。Y. enterocolitica は2448時間培養で本培地上に平滑、赤色、湿潤でやや膨隆、コロニーの周辺が白色をおびた特徴
CIN 寒天培地は、検査材料からのYersinia の選択分離培地です。Y. enterocolitica は2448時間培養で本培地上に平滑、赤色、湿潤でやや膨隆、コロニーの周辺が白色をおびた特徴+もっと見る
JNC MCMedia Pad SA 黄色ブドウ球菌用 (1000枚) SK03A25
手軽にかつ正確な微生物検査が可能です。サンプルを培地パッドに滴下するだけですので、不慣れな方でも取り扱いが容易です。経験の差が出にくくなります。
手軽にかつ正確な微生物検査が可能です。サンプルを培地パッドに滴下するだけですので、不慣れな方でも取り扱いが容易です。経験の差が出にくくなります。+もっと見る